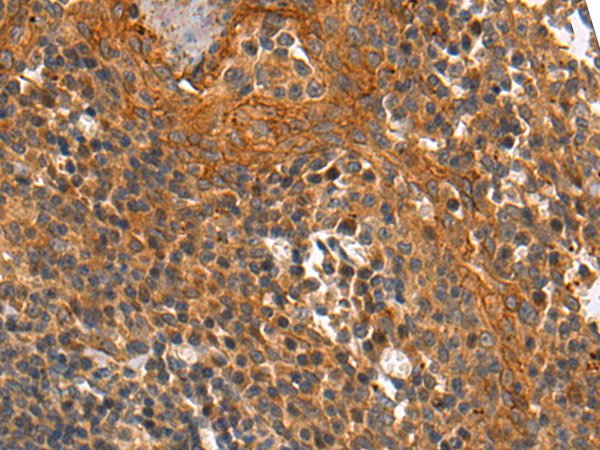
一抗

|
ackground: |
Kallikreins are a subgroup of serine proteases having diverse physiological functions. Growing evidence suggests that many kallikreins are implicated in carcinogenesis and some have potential as novel cancer and other disease biomarkers. This gene is one of the fifteen kallikrein subfamily members located in a cluster on chromosome 19. Alternate splicing of this gene results in three transcript variants encoding different isoforms. |
|
Applications: |
ELISA, IHC |
|
Name of antibody: |
KLK12 |
|
Immunogen: |
Synthetic peptide of human KLK12 |
|
Full name: |
kallikrein related peptidase 12 |
|
Synonyms: |
KLKL5; KLK-L5 |
|
SwissProt: |
Q9UKR0 |
|
ELISA Recommended dilution: |
2000-5000 |
|
IHC positive control: |
Human brain |
|
IHC Recommend dilution: |
10-50 |


 購(gòu)物車(chē)
購(gòu)物車(chē) 幫助
幫助
 021-54845833/15800441009
021-54845833/15800441009